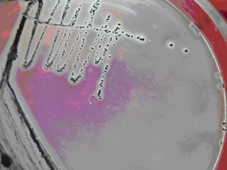

海博微信公众号
海博微信公众号
 海博天猫旗舰店
海博天猫旗舰店


 海博微信公众号
海博微信公众号
 海博天猫旗舰店
海博天猫旗舰店




金黄色葡萄球菌是人类化脓感染中最常见的病原菌,可引起局部化脓感染,也可引起肺炎、败血症等,其毒性的强弱取决于产生的毒素和侵袭性酶,例溶血素酶、杀白细胞素、血浆凝固酶、脱氧核糖核酸酶。
B-P琼脂上金黄色葡萄球菌有黑色的菌落中心,周围有半透明的卵磷脂沉淀环。
甘露醇卵黄琼脂上的特征是菌落黄色,周围也有卵磷脂沉淀环。
甘露醇高盐琼脂上的菌落特征与甘露醇卵黄琼脂上的菌落特征相同,不过,菌落周围没有卵磷脂沉淀环。
检样中常见的问题:
1、 平板的状态。透明、有絮状物。
2、 凝固酶实验的观察。
原因:1、不同的厂家的培养基平板制好后的状态有所不同,主要取决于亚碲酸钾卵黄增菌液的不同,我们公司采用的鸡蛋是山鸡蛋,卵磷脂含量较高,因此,制备好的平板一般透明度较好,接种金黄色葡萄球菌后,菌落特征较易观察。此外,在添加亚碲酸钾卵黄增菌液时,温度的掌握,不宜太高,过高易使卵黄变性,也不应太低,太低琼脂易凝固。
3、 将金黄色葡萄球菌接种到兔血浆上后,每半小时观察一次,观察凝固时,将血浆轻轻倒置,如有流动既证明没有凝固。如若不明显,可补做DNA酶实验。

上一篇:大肠菌群检测注意事项



